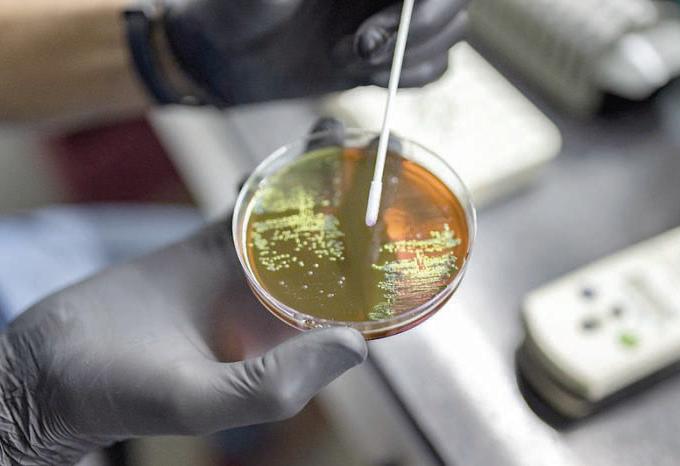
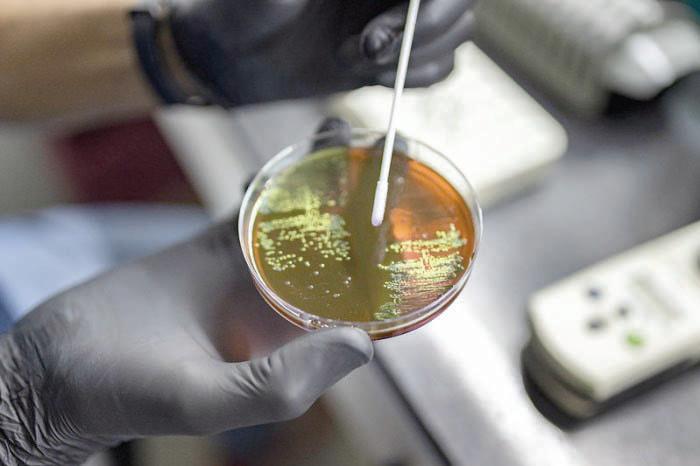

EL HERALDO DE XALAPA

HERALDO DE
Director General
Dr. Rubén Pabello Rojas
Director Corporativo
Ing. Eduardo Sánchez Macías
Director editorial
Lic. Rafael Meléndez Terán

Director Comercial
Lic. José de Jesús López Hernández
Jefa de Redacción
Lic. Ivonne Méndez
El Heraldo de Xalapa es una publicación de lunes a sábado. Editor responsable Ing. Eduardo Sánchez Macías. Número de Certificado de Reserva de Derecho al Uso Exclusivo del título 04-2010052510203900-101. Certificado de Licitud de Título: 15357 Certificado de licitud de contenido 15357. Domicilio de la publicación, impreso y distribuido por El Heraldo de Xalapa, con domicilio en Ávila Camacho No. 10, Col. Centro, C.P. 91000, Xalapa, Ver. TEL. 01 (228) 8419552, 8419319, 841 9363 y 841 9437. elheraldodeveracruz@gmail.com
Gerente Administrativo
L.A.E. María del Socorro López Lagunes
Jefe de Publicidad
Lic. Óscar Rojas Barradas
























NUDO GORDIANO
YURIRIA SIERRA
El fallecimiento de Paul Auster marca el final de un capítulo importantísmo en la literatura contemporánea. Su pluma, afilada y profunda, exploró con maestría las complejidades del alma humana y la dinámica cambiante de la sociedad occidental en las últimas décadas. Auster fue más que un escritor prolífico, fue un cronista de los tiempos modernos, cuyas historias y personajes capturaron la esencia del modus vivendi de la era contemporánea, además de plantear cuestiones filosóficas urgentes que resonarán mucho después de su partida. Auster capturó, como pocos, los dilemas existenciales de la modernidad tardía. Sus novelas exploraron con agudeza los temas del azar, la identidad fragmentada y los laberintos del lenguaje y la memoria en una sociedad líquida y cambiante.
La obra de Auster, especialmente su Trilogía de Nueva York, no sólo estableció su lugar como uno de los escritores más influyentes de su generación, sino que también ofreció un espejo en el que los lectores de Occidente pudieron ver reflejadas sus propias vidas y preocupaciones. Sus historias, a menudo situadas en los rincones urbanos y sombríos de la ciudad de Nueva York, sirvieron como un microcosmos de la vida moderna, abordando temas como la soledad, la alienación, la identidad y la búsqueda de significado en un mundo cada vez más caótico y desconectado. Auster tuvo una habilidad inigualable para tejer complejas tramas metafísicas que desafiaban las percepciones de la realidad, la autoría y la existencia misma. En sus narrativas, los personajes a menudo se encontraban cuestionando sus propios roles y motivaciones, reflejando el mismo tipo de introspección que ha definido la modernidad en Occidente. Su estilo literario, que fusionaba lo surrealista con lo mundano, lo filosófico con lo cotidiano, resonó con lectores que, en sus propias vidas, luchaban por reconciliar estas mismas dualidades.
Más allá de sus contribuciones literarias, Auster fue un defensor apasionado de la cultura y la literatura. Su compromiso con las artes y su activismo político demostraron su entendimiento de que la literatura no es sólo un medio de entretenimiento, sino además una herramienta crucial para comprender y cuestionar la realidad de la sociedad completa. Auster creía en la capacidad de la narrativa para iluminar la experiencia humana y, a través de sus libros y su activismo, defendió una visión de la literatura como un puente entre las diferentes facetas de la vida moderna. El legado de Paul Auster no se limita sólo a sus libros, sino que también incluye su impacto en la cultura y la forma en que Occidente se percibe a sí mismo. Su capacidad para explorar las tensiones internas y externas de la modernidad ha dejado una huella indeleble en la literatura contemporánea, ofreciendo a los lectores no sólo entretenimiento, sino también una oportunidad para reflexionar sobre sus propias vidas y el mundo que los rodea. En un momento en que la cultura occidental enfrenta cambios rápidos y a menudo desconcertantes, la pérdida de una voz tan significativa como la de Auster es un recordatorio de la importancia de la literatura como un faro en la oscuridad. Su obra, con su estilo distintivo y su profundo análisis de la condición humana, continuará siendo una fuente de inspiración y reflexión para generaciones futuras.
La partida de Paul Auster marca el fin de una era en la literatura contemporánea, pero su legado perdurará, guiando a los lectores en su exploración de las cuestiones filosóficas y culturales que continúan dando forma a Occidente. En sus páginas, encontraremos no sólo historias fascinantes, sino también un mapa para navegar las complejidades de la vida moderna y posmoderna, recordándonos la importancia de la literatura como un medio para comprendernos a nosotros mismos y el mundo que nos rodea.
OPINIÓN
Día del niño, pero en nuestros tiempos ¿qué es ser niño?
ANTONIO VERA HERNÁNDEZ
Según el artículo 1° de la Convención de los Derechos del Niño, se define como niño y niña a “todo ser humano menor de 18 años de edad, salvo que, en virtud de la Ley que le sea aplicable, haya alcanzado antes la mayoría de edad”
En la actualidad los derechos de la infancia han sido reconocidos incluso sobre los derechos fundamentales de los adultos; pero la desafortunada etapa por la que la humanidad en está transitando, en la abrupta carencia de valores y en la vida menos interesada en la base fundamental de cualquier sociedad sana, que es la familia.
La desestructura familiar que ha hecho que la niñez en nuestros tiempos se encuentre en graves y complicados problemas de supervivencia, lo que ha generado que los menores cursen por una época de verdadera vulnerabilidad en nuestro país y el mundo.
En el México de 2024, puede validarse que los derechos de la infancia son día a día vulnerados, principalmente por sus padres, como principales garantes de su debido desarrollo y progreso como seres humanos.
La atención, la alimentación, el cariño, la protección, la vigilancia y sobre todo la estimulación intelectual que deben ser proporcionados por sus progenitores permitirían a las niñas y niños desarrollar la seguridad y autoestima necesarias, para convivir en el entorno social que se desarrollan sanamente.
La familia, la comunidad, la escuela y el gobierno, son esenciales para el desarrollo de los menores y deben ser consideradas como obligación de los padres proporcionarlos a los hijos en la medida de sus posibilidades, pero siempre buscando su debida protección, respeto y cuidado.
Debe entenderse que las niñas, niños y adolescentes son responsabilidad de sus padres, familias y luego del Estado; y no en sentido contrario; los padres por ley están obligados a garantizar el sano desarrollo de sus hijos hasta en tanto éstos
cuenten con la capacidad de tomar sus decisiones. El respeto y protección de los derechos de la infancia dejaría atrás en gran medida el lacerante fenómeno que como antecedente existe en México, el de “las niñas y niños en condición de calle”, anomalía ciudadano-gubernamental que daña profundamente al tejido social; pues, los menores que apenas conscientes de su existencia, ya son ejemplo de vulneración de un amplio abanico de derechos, ya reconocidos como humanos. Niños, niñas y adolescentes con presentes sombríos y futuros desoladores.
Las niñas, niños y adolescentes en situación de calle no son más que pequeños desolados y abandonados por sus padres; sin embargo, en la actualidad en México, esta desolación y abandono es una responsabilidad compartida con el Estado; pues la pobreza ha crecido de manera incontrolable y desmesurada; y, ello ha hecho que exista una imposibilidad latente de poder otorgar a los hijos una vida en perfecto desarrollo, se ha retrocedido más de 20 años en Educación; se han recortado mas de 103 mil mdp en programas de educación y salud; desaparecieron las escuelas de tiempo completo; no hay medicamentos ni servicios de salud eficientes, ni tratamientos para niños con cáncer u otras enfermedades terminales; los padres tienen que trabajar ahora jornadas extraordinarias para cubrir las necesidades básicas de sus menores hijos y con ello la convivencia y el cuidado de los menores la dejan a cargo de los abuelos y familiares cercanos que en el mejor de los casos cuidan de ellos; pero que en la realidad ha sido documentado que de igual manera sufren maltrato, abusos y hasta abandono. NO perdamos la esperanza, en junio podemos abonar para el cambio y lograr que nuestros hijos tengan una mejor oportunidad de vida. Y tú ¿qué opinas? ¿Qué clase de infancia quieres para tus hijos?

Luego de que la canciller Alicia Bárcena expresó este miércoles su rechazo a la ley antiinmigrante HB4156 en Oklahoma, el Gobierno de México expuso su preocupación por la aprobación de “La ley de seguimiento y denuncia de extranjeros criminales de Georgia de 2024” (“The Georgia Criminal Alien Track and Report Act of 2024” o Georgia HB1105).
Las prácticas discriminatorias y de perfilamiento racial, así como la potencial disminución de las denuncias en las agencias de orden público por el temor a repercusiones migratorias son conductas que preocupan al gobierno mexicano.
Ante esta situación, México reafirmó su compromiso de proteger y defender los derechos de las personas mexicanas en el exterior.
Indicó que a través de la
representación consular en Atlanta, se reforzarán las medidas de asistencia y protección consular para garantizar “una respuesta rápida y efectiva a cualquier violación de derechos que puedan enfrentar nuestros connacionales como resultado de la implementación de esta nueva ley”.
La Cancillería resaltó que la comunidad mexicana es fundamental para Georgia, donde los hispanos constituyen más del 11% de la población total.
El comercio total entre México y Georgia alcanzó los 18.6 mil millones de dólares en 2023, generando 150 mil empleos en el estado, informó.
La SRE reiteró el llamado a toda la comunidad en Georgia para que se acerque al Consulado General de México en Atlanta ante cualquier necesidad de asistencia o protección y puso a disposición el Centro de Atención y Asistencia a Personas Mexicanas (CIAM) en el número 520-623-7874.

EL UNIVERSAL CIUDAD DE MÉXICO
El presidente Andrés Manuel López Obrador afirmó que en casi seis años de gobierno ha logrado revertir las tendencias “antiobreras” que caracterizaron al régimen neoliberal y entreguista, por lo que exclamó: “misión cumplida”.
Al conmemorar el Día Internacional del Trabajo, en una comida con líderes sindicales y trabajadoras del hogar, el Presidente de México destacó que esos cambios se han hecho de la mano de trabajadoras y trabajadores determinados a transformar al país.
“Al hacerlo juntos como ya lo expresé: hemos hecho historia”, aseguró el Mandatario en su mensaje en el Salón Tesorería de Palacio Nacional.
El jefe del Ejecutivo hizo un balance de la política labo-
ral de su gobierno como el aumento al salario mínimo de más del 100 % con el apoyo empresarial, el aumento al salario de los trabajadores de la educación, el mantener el desempleo en un índice más bajo del mundo; el crecimiento en el reparto de utilidades y la cancelación de la subcontratación.
En materia de democracia sindical –dijo- se logró el voto libre y secreto en elección de dirigentes, la no injerencia del gobierno en la vida de los sindicatos, garantías plenas para ejercer en libertad el derecho de huelga. “No se ha reprimido a los trabajadores ni hay persecución para los dirigentes sindicales”.
Así como la promulgación del decreto presidencial para crear Fondo de Pensiones para el Bienestar, entre otros cambios legales.
“Hemos enfrentado resis-
tencias de grupos conservadores que en sentido estricto no son precisamente todos empresarios, sino traficantes de influencias y especuladores financieros, acostumbrados a medrar; sin embargo, hemos podido seguir adelante con el apoyo de la mayoría de nuestro pueblo hemos y así continuaremos hasta el final de nuestro mandato”.
Destacó que lección de estos años es que no se puede transformar un gobierno de injusticia y opresión sin el respaldo del pueblo y para contar con el respaldo del pueblo se necesita poner en el centro las demandas de las mayorías.
“Hay algo que debe saberse los pobres no traicionan, los pobres son leales, no se puede estar pensando en una transformación, que va a ser apoyada por las élites, eso es una contradicción eso es muy difícil de lograr”.
El Instituto Nacional Electoral (INE) reincorporará a la Lista Nominal en el Extranjero a 24 mil 787 personas que fueron excluidas por inconsistencias o irregularidades en sus registros, mientras que el resto sigue en proceso de revisión hasta el 5 de mayo.
En entrevistas con EL UNIVERSAL, Sofía Sánchez y Renata Fernández podrán ejercer su voto ante los comicios del próximo 2 de junio, mientras que Carlos Arriola continuará con el trámite hasta el 5 de mayo.
Renata Fernández, de 46 años, quien reside en España, explicó que hizo su trámite desde noviembre de

2023 y fue notificada que no podría realizar su voto el próximo 2 de junio, por lo que volvió a realizar el procedimiento para ejercer su derecho desde el extranjero.
semanas el INE notificó que tenía inconsistencias con su documentación. Sin embargo, Sánchez no confía mucho con la nueva notificación del INE, aunque volvieron a incorporarla en la Lista Nominal.
“Me respondieron por email que siempre sí en la práctica me da miedo que no, estoy siendo desconfiada”, explicó.
“El INE me envió un correo diciendo que me incluían de nuevo en la Lista Nominal, parece que estamos jugando”, aseguró.
De igual forma Sofía Sánchez, quien reside en California, Estados Unidos, desde enero del presente año, recibió la notificación que podría ejercer su sufragio el próximo 2 de junio, pero hace unas
Asimismo, Carlos Arriola, quien reside en Barcelona, España, expresó que hace meses recibió el visto bueno para participar en los próximos comicios en México, de igual forma volvió hacer el trámite, pero no ha sido incorporado a la Lista Nominal.
“Me llamaron del INE, envié los documentos, me los rechazaron y hoy enviaré otra vez, espero tener suerte”, enfatizó.
La Secretaría de Hacienda y Crédito Público (SHCP) actualizó el subsidio al empleo para los trabajadores asalariados, beneficio que se había perdido con el aumento del salario mínimo.
“Hoy hemos actualizado el subsidio al empleo, ya que, con el aumento del salario mínimo, el sistema anterior quedó obsoleto. Este ajuste aplica para trabajadores que ganan hasta 9,000 pesos”, escribió el subsecretario del ramo, Gabriel Yorio González en sus redes sociales.
En un post en su cuenta X (antes Twitter), el funcionario federal también destacó que “además, esta actualización reduce la carga de impuestos para los trabajadores y facilita el proceso para los empleadores”.
Yorio hizo referencia al decreto que publicó este miércoles 1 de mayo la SHCP en el Diario Oficial de la Federación (DOF) en una edición vespertina.
En el decreto se pone de manifiesto que el incremento progresivo en los salarios y el salario míni-

mo ha provocado que el subsidio para el empleo pierda efectividad como mecanismo de apoyo fiscal al ingreso de los trabajadores.
Se reconoce que lo anterior causó que aquellos que antes se beneficiaban con el subsidio para el empleo, enfrentaban una mayor carga tributaria, debido a que la tabla del artículo 1.12. del decreto que compila diversos beneficios fiscales, quedó superada al establecer como máximo límite superior, ingresos por siete mil 382 pesos.
Por esa razón, fue conveniente modificar el procedimiento del cálculo del subsidio al empleo, para sustituir la tabla actual de montos
variables por una cuota mensual equivalente al 11.82% del valor mensual de la Unidad de Medida y Actualización (UMA), aplicable de manera uniforme a todos los trabajadores cuyo salario mensual no exceda los 9 mil 81 pesos, con el propósito de disminuir el impuesto sobre la renta (ISR) a su cargo.
Argumentó que se ha observado que las empresas que contratan trabajadores que perciben el salario mínimo, tienden a otorgar remuneraciones aproximadas o superiores a ese nivel, por lo cual se considera adecuado establecer el límite de nueve mil 81 pesos.
De tal manera que para el ejercicio fiscal de 2024, el porcentaje de 11.82% representa un monto mensual de 390 pesos, cuya aplicación permite que el aumento en el ingreso disponible de los trabajadores después del IRS respectivo, sea proporcional al aumento del 20% del salario mínimo general de 2024.
Expuso que ese monto mensual, es 1.79 veces el importe del último monto del subsidio para el empleo de la tabla vigente, lo que representa un beneficio fiscal más significativo para los trabajadores.
CIRT acusa que el INE quiere obligar a cubrir a Álvarez Máynez
EL UNIVERSAL CIUDAD DE MÉXICO
El pasado 30 de abril, cientos de estaciones de radio y televisión públicas y privadas fueron notificadas sobre una sanción del Instituto Nacional Electoral (INE) requerida por Movimiento Ciudadano para obligar a cubrir a su candidato Jorge Álvarez Máynez. Ante el hecho, la Cámara Nacional de la Industria de Radio y TV (CIRT) acusó que este es un “ataque frívolo” hacia la libertad de expresión. Asimismo, aseguró que es un acto intimidatorio de MC.
“En el mismo sentido, es un atentado a la libertad de expresión pedir que cada comunicador entregue al INE su “estrategia de cobertura noticiosa”, cuando justo se va conformando día a día, sobre la marcha, conforme se da la coyuntura de las campañas electorales.”, escribió en un comunicado.
PorloqueaseguróqueMovimientoCiudadanonotiene sustento legal para regular las redes sociales o plataformas de internet. “Todo ello es censor y retrógrado”, afirmó. La CIRT aseguró que dará apoyo jurídico a las estaciones afectadas y presentará una denuncia ante el INE por el ataque frívolo y sin sustento contra la radiodifusión y sus comunicadores.
“Se procederá legalmente contra el Encargado del Despacho de la Unidad Técnica de lo Contencioso Electoral de la Secretaría Ejecutiva del Instituto Nacional Electoral, Hugo Patlán Matehuala, por haber dado trámite a una denuncia a todas luces ilegal y violatoria de la normatividad y frívola”, dijo. Finalmente, la CIRT pidió a los partidos y sus candidaturas a tener propuestas de “altura” y evitar actos intimidatorios “cuando la radio y TV son el principal medio por el que se informa el electorado”.
EL UNIVERSAL
CIUDAD
Desde hace más de medio siglo, los principales organismos e instituciones especializadas en salud mental han coincidido al señalar que la homosexualidad no es un trastorno ni una enfermedad física o mental. Sin embargo, aún hay profesionales con información arcaica o personas con ciertas convicciones religiosas que buscan “redirigir” las orientaciones sexuales e identidades de género de personas que han llegado con ellos recomendados, o o engañados, por familiares o amigos afirmó Tania Esmeralda Rocha Sánchez, Investigadora de la Facultad de Psicología (FP) de la UNAM.
“En el México del siglo XXI aún hay quienes buscan modificar la orientación no normativa mediante violencia física, psicológica o sexual. A estas estrategias se les conoce como terapias de conversión o esfuerzos para corregir la orientación sexual e identidad de género (ECOSIG). A eso no se le puede llamar ‘terapia’ porque no hay nada que curar”, destacó. También explicó que el daño causado por estas prácticas es variable y tiene secuelas: “Las violaciones correctivas suelen emplearse con adolescentes lesbianas o bisexuales, muchas veces por parte de algún conocido o familiar, y ello tiene un impacto brutal en la psique. Estas acciones abonan a que las personas LGBTIQ+ lleguen a percibirse fuera de lo normativo y desarrollen una homofobia

o transfobia interiorizadas que pueden derivar en depresión o ideación suicida”.
El pasado 26 de abril y después de casi seis años de haberse presentado la iniciativa en el Senado, se logró que las mal llamadas terapias de conversión se prohibieran en todo México. El Senado aprobó las reformas al Código Penal y a la Ley General de Salud para prohibir y sancionar los ECOSIG, con los que se intenta obligar a las personas a cambiar su identidad sexual.
Las modificaciones que se han logrado incluyen sanciones y penas de entre dos y seis años de cárcel para quienes participen de alguna forma con la realización o financiación de este tipo de prácticas y se duplican si las víctimas son personas menores de 18 años, adultos mayores o con alguna discapacidad.
Asimismo, expuso que existen “terapias” en la que los sujetos son aislados y sometidos a acciones equivalentes a un secuestro o torturados. Lo más grave es que dichas vejaciones suelen quedar impunes y guardarse como secreto debido a las amenazas que lanzan los violentadores contra sus víctimas.
“Estas estrategias datan de hace mucho, aunque apenas comienzan a nombrarse. Por ejemplo, en los campos nazis había procesos parecidos donde a los homosexuales se les torturaba bajo la creencia de que así regularían sus hormonas y su orientación. Aunque éstas son prácticas de antaño, hoy son más visibles porque estamos rompiendo el silencio y porque cada vez hay más víctimas y grupos que, desde el activismo o la academia, señalan que esto es una agresión
que debe parar”, especificó. El país ha tenido un proceso de homofobia histórica en el cual se pasó de considerar a la homosexualidad como delito a verla como un pecado y una enfermedad. En contraste, los avances científicos han llegado a corroborar —de manera sistemática y contundente— que ni la homosexualidad, las identidades trans o las expresiones de género no binarias son un problema de salud mental.
“En todo caso, aquellos padecimientos o malestares de carácter psicológico o emocional que las personas LGBTIQ+ llegan a experimentar son resultado de un entorno hostil, violento y de rechazo, discriminación o prejuicio, pero no algo per se de la identidad o de cómo ésta se expresa al mundo”, aclaró la académica.
Según la Asociación Internacional de Lesbianas, Gays, Bisexuales, Trans e Intersex, en el mundo sólo 16 países han prohibido los ECOSIG a nivel nacional por el daño emocional, físico y por la vulneración a los derechos humanos que provocan, algunos de estos países son: Brasil (1999), Ecuador (2012), Malta (2016), Canadá, Francia, Grecia, Israel, Nueva Zelanda, Vietnam (2022), Bélgica, Chipre, España, Islandia, Noruega (2023), Portugal y México (2024).
Para Tania Rocha, aunque esto es de celebrarse, también debe considerarse apenas como una iniciativa entre muchas otras que deben instrumentarse a fin de que la gente entienda que la orientación sexual no es algo que deba corregirse.
EL UNIVERSAL
TUXTLA GUTIÉRREZ, CHIS
Familiares del empresario, Adolfo Miguel Talango, secuestrado por un grupo de indígenas tzeltales del municipio de Altamirano, el jueves 25 de abril, pidieron que lo liberen, porque “no es funcionario”, ni tiene ningún vínculo con la presidenta del concejo municipal María García López, que también fue raptada.
La madre de Adolfo Miguel Talango, de 44 años de edad, Irma Alicia Talango Vázquez, dio a conocer que su hijo radica en Tuxtla, pero cada fin de semana viaja a Ocosingo, para hacer cuentas con los encargados de un hotel de su propiedad que tiene en ese lugar. El jueves por la mañana pretendía regresar a Tuxtla, pero al momento que fue a desayunar a un restaurante de Ocosingo, donde también se encontraba María García López y el tesorero municipal, Juan Montaño, fueron sorprendidos por militantes de una organización identificada como Comach.
Los hombres que llegaron a bordo de varios vehículos, se llevaron a María García López, el tesorero y otras personas que para ese momento desayunaban en el restaurante.
Talango Vázquez pidió la liberación de su hijo, porque es “ajeno” al conflicto que se vive en el municipio de Altamirano.
“Lo único que pido es que regrese. Que me lo liberen. Que yo lo vea entrar por esta puerta sano y salvo. La verdad es lo único que pido y que se toquen su corazón ellos si tienen madre”, expuso.
En un video, que envió la presidenta del concejo municipal de Altamirano, María García López, el sábado 27 de abril, dice encontrarse en buen estado de salud, igual que sus acompañantes y asegura que fue detenida por incumplimiento en obras y entrada de recursos a habitantes de una comunidad.
La esposa de Aldolfo Miguel Talango, Elizabeth Sánchez asegura su esposo fue raptado el jueves 25 de abril a las 09:30 horas. “Lamentablemente estaba en el lugar no indicado. Llegaron estas personas y las llevaron. Arrasaron con los que estaban ahí (en el restaurante)”. Expuso que hay varias versiones de que los indígenas tzeltales se llevaron a la presidenta del concejo municipal y tres más, aunque otros aseguran que son cinco u ocho los comensales que también fueron raptados. “En un video dice la presidenta que está con tres personas más. Entre ellos su esposo”, explicó. La familia del empresario no ha interpuesto ninguna demanda ante la Fiscalía de Chiapas, porque lo único que pide es que lo regresen, porque “nada tiene que ver en el conflicto”. El municipio de Altamirano está sumido en un conflicto poselectoral desde el 2021, cuando habitantes se opusieron a que la esposa de Roberto Pinto Kanter, del PVEM, Gabriela Roque Tipacamú, que ganó la elección asumirá el cargo, porque consideraron que la familia Pinto-Roque se rotaba el poder y estaban a punto de entrar a más de 10 años de acaparar la alcaldía.

Una persecución entre presuntos integrantes de grupos delictivos antagónicos generó temor, debido a que los vehículos traspasaron la caseta de seguridad en el exclusivo complejo residencial de Bernárdez, ubicado en el municipio de Guadalupe en Zacatecas. Esto generó que se desplegara un fuerte operativo de seguridad en el lugar y dentro de los resultados oficiales que se han reportado es la detención de una persona, así como aseguramiento de droga y un vehículo.
Los hechos ocurrieron pasado el mediodía con una persecución que inició sobre la Avenida Pedro Coronel, en el municipio de Guadalupe, todo apunta a que un grupo delictivo trató de dar alcance al conductor de un vehículo color amarillo, luego otros autos ingresaron evadiendo la caseta de seguridad de esa zona residencial, donde se presume que uno de ellos reside.
El tripulante del vehículo al intentar huir generó diversos destrozos, hasta que finalmente perdió el control y chocó, mientras que los demás autos se dieron a la fuga. De acuerdo con la información actualizada que ha proporcionado la Fiscalía General de Justicia
EL UNIVERSAL
CIUDAD JUÁREZ, CHIH
Un grupo de 104 migrantes de diversas nacionalidades fueron rescatados de una vivienda en la que los tenían retenidos. El rescate lo llevó a cabo la Secretaría de Seguridad Pública del Estado adscritos a la Fuerza Especial SWAT, con base a una denuncia realizada al 9-1-1 mediante la cual se reportó el ingreso de personas armadas al interior de un domicilio ubicado en el cruce de las calles Ricardo Marquina y Carlos Alonso del Real de la Colonia Infonavit Casas Grandes.
Los denunciantes señalaron, que se escuchaban gritos de auxilio del interior de la vivienda, por lo cual al arribar al cruce antes mencionado, los agentes se percatan de la presencia de un hombre con vestimenta playera negra y pantalón de mezclilla, quien al percatarse de la presencia de los oficiales saca de la cintura un arma de fuego tipo pistola e ingresa de manera inmediata al domicilio señalado.
Una vez en el exterior de la vivienda, los agentes confirman que se escuchan gritos de auxilio, por lo que optaron por ingresar de manera inmediata para salvaguar-

de Zacatecas se precisa que como resultado en la atención al reporte informado, “elementos de la Policía Estatal lograron la detención de un sujeto masculino, mismo que conducía un vehículo marca Chevrolet, color amarillo, unidad automotor que minutos antes había sido perseguido por dos automóviles, los cuales ingresaron a alta velocidad al fraccionamiento”.
Se especifica que el motivo de la detención de la persona se debe a los daños que causó en dos inmuebles, ubicados al interior del complejo residencial Bernárdez, así como por delito
contra la salud, ya que se confirma que el sujeto estaba en posesión de narcóticos, además de aclarar que se le investigará por los delitos que resulten con motivo de la investigación. De igual manera se menciona que “se tiene registro que los responsables de los otros dos vehículos involucrados salieron del fraccionamiento, por lo que se mantiene un despliegue coordinado en la zona metropolitana con el objetivo de lograr su pronta localización” y se afirma que no se reportan personas lesionadas y la situación ya se encuentra controlada.
Rescatan a 104 migrantes retenidos en una vivienda en Chihuahua

dar la vida e integridad de terceras personas.
Con la intervención, se logró el aseguramiento de la persona armada, quien portaba una pistola calibre .45, así como 3 masculinos que amedrentaban a personas sometidas en el piso, por lo que procedieron también a su aprehensión.
Los detenidos fueron identificados como Johan Ricardo R. E. de 21 años, Carlos Iván M. G. de 27 años, José Gerardo S. M. de 41 años y Luis Carlos C. B. de 20 años, a quienes se les aseguró el arma de fuego, así como 10 cartuchos útiles, mismos que fueron puestos a disposición de la Fiscalía General de la República,
para las indagatorias correspondientes.
Tras la detención de los presuntos delincuentes, los agentes procedieron a verificar la salud y el estado físico de las personas que permanecían allí, quienes informaron que su intención era cruzar hacia Estados Unidos.
Entre las personas, se localizaron: 17 personas provenientes de otros estados de México, 25 de El Salvador, 54 de Guatemala, 07 de Ecuador y 01 de Honduras. Las personas localizadas fueron puestas a disposición del Instituto Nacional de Migración (INM), de igual forma se dio parte a la Comisión Estatal de Derechos Humanos.


Les aseguraron armas de fuego, cartulinas con amenazas propias de un grupo delictivo y más de 300 dosis de estupefacientes.
REDACCIÓN
Gracias a una denuncia ciudadana, efectivos de la Secretaría de Seguridad Pública (SSP), a través de Policía Estatal atraparon a integrantes de una célula delincuencial por delitos contra las instituciones, portación ilegal de armas de fuego y delitos contra la salud.
Los oficiales fueron alertados sobre la venta de estupefacientes en la localidad Las Granjas en Poza Rica. Al llegar al lugar observaron a cinco hombres y una mujer junto a dos motocicletas Italika, sin placas.
En ese momento las personas comenzaron a realizar disparos con arma de fuego en contra de los uniformados, hasta ser detenidos. Acto seguido, le realizaron a Brayan Ulises “N”, Luis Alberto “N”, Uriel “N”, Luis “N”, José Alberto “N” y Zoila “N” una revisión a sus pertenencias y les aseguraron cuatro armas de fuego cortas, cargadores, cartuchos útiles, chaleco táctico y dos armas blancas.
Además de 386 dosis y seis bolsitas de una sustancia granulada parecida al cristal, 34 bolsitas y un paquete con hierba verde similar a la marihuana, una báscula gramera y dos cartulinas con mensajes amenazantes alusivos a la delincuencia organizada.
Los seis detenidos relacionados a los últimos hechos violentos en la zona, quedaron a disposición de la autoridad correspondiente, para los trámites de ley.




pegaron por detrás

REDACCIÓN
MARTÍNEZ DE LA TORRE
Destrozada la facia quedó un auto después de que una camioneta lo impactara por detrás, un oficial de Tránsito acudió al lugar para tomar conocimiento del accidente.
MARTÍNEZ DE LA TORRE
Un individuo que aparentemente intentaba darse a la fuga para evitar ser intervenido por un oficial de tránsito, terminó por accidentarse cuando accidentalmente chocó con una de las motopatrullas de la corporación, el joven se lesionó por lo que tuvo que ser atendido por paramédicos de Cruz Roja Mexicana.
Fue alrededor de las 9:00 horas en el cruce de la calle Guadalupe Victoria y la avenida 5 de Febrero, en donde el motociclista identificado como Erick P. L., de 30 años de edad, originario de la colonia Ejidal de este municipio, viajaba a bordo de una motocicleta de la marca Vento en compañía de una mujer.
De acuerdo con información extraoficial, este fue intervenido por el personal de la Dirección de Tránsito, sin embargo, al momento de pretender evitar ser intervenido este accidentalmente chocó contra el manubrio de la moto-patrulla por lo que terminó por caerse al piso este resultó con una lesión en el cuello por lo que tuvo que ser auxiliado por paramédicos de Cruz Roja Mexicana.
Al sitio también arribaron elementos de la Policía Municipal para tomar conocimiento del hecho.
Fue a las 17:00 horas en el crucero de la calle Ignacio Allende y avenida 5 de Febrero, por dónde circulaba un automóvil marca Nissan, de la línea Sentra, con placas de circulación YKM-384-B del estado, al pasar por dicho crucero fue impactado por una camioneta. La unidad responsable fue una
POR
QUERER DARSE A LA FUGA
Ford, tipo Ranger, con placas de circulación XW-1548-A del estado, no presentó daño, el conductor no guardó su distancia. Al sitio acudió un oficial de Tránsito Municipal para tomar conocimiento de lo sucedido y ambas partes le comentaron que ya habían llegado a un buen arreglo.








AVC NOTICIAS
XALAPA
La Comisión Estatal de Búsqueda del Estado de Veracruz (CEB) reportó la desaparición de cinco personas en distintos municipios de la entidad veracruzana y solicita el apoyo de la población para dar con su localización.
La ficha 24/CI 0252U-24ZC reporta la desaparición de Joaquín de Jesús Hernández Arano, de 22 años de edad, con quien se perdió el contacto el pasado 26 de marzo de 2024 en Medellín de Bravo, Veracruz.
La ficha 24/SB 0604U-24ZS reporta la desaparición de Adrián Escribano Durán, de 29 años de edad, con quien se


perdió el contacto el pasado 22 de abril de 2024 en Acayucan, Veracruz.
La ficha 24/CI 0251U-24ZC reporta la desaparición de Sahira Vanessa Reyes Valladares, de 32 años de edad, con quien se perdió el contacto el pasado 28 de marzo de 2024 en Veracruz, Veracruz.
La ficha 24/SB 0606U-24ZS reporta la desaparición de Benjamín Guatemala

Pio, de 35 años de edad, con quien se perdió el contacto el pasado 24 de abril de 2024 en Miguel Hidalgo y Costilla, Santiago Tuxtla, Veracruz. La ficha 24/CI 0250U-24ZC reporta la desaparición de Guadalupe Hernández Palmeros, de 35 años de edad, con quien se perdió el contacto el pasado 22 de marzo de 2024 en Veracruz, Veracruz.

estacionada por unos minutos frente al Ingenio San Miguelito, en el municipio de Córdoba.
Amantes de lo ajeno robaron tres camionetas particulares cuando se encontraban estacionadas en calles de Córdoba y Orizaba; los afectados ya interpusieron una denuncia por robo ante las autoridades de la Fiscalía con la finalidad de recuperar sus herramientas de trabajo.
La primera unidad reportada como robada, fue una Nissan de redilas estaquitas de color blanco, con caja de redilas metálica y lona azul, la cual fue dejada
La segunda unidad robada en la Ciudad de Córdoba, fue una Chevrolet tipo Suburban, con placas de circulación YRN573B del Estado de Veracruz, modelo 1994 y de color vino con plata, la cual se encontraba estacionada en el cruce de la Avenida 25 esquina Calle 5 de la colonia El Carmen.
Ambos robos fueron reportados a los números de emergencia 911, arribando a dichos lugares oficiales de la Policía
Municipal y Estatal, quienes únicamente tomaron conocimiento e implementaron un operativo de búsqueda de localización, aunque los resultados fueron negativos.
Los propietarios presentaron la denuncia formal por robo ante la Fiscalía Regional Zona Centro-Córdoba en contra de quién o quiénes resulten responsables.
Mientras que, en Orizaba, también fue robada una camioneta, Chevrolet GMC Suburban, de color negro y con placas de circulación: YJK1576 del Estado de Veracruz, cuando se encontraba estacio-
nada sobre la calle Emiliano Zapata de la colonia Benito Juárez, en la zona Sur de la Pluviosilla.
Dicho robo fue cometido durante la madrugada por personas desconocidas que aprovecharon la nula vigilancia de la Policía Municipal. Más tarde, el agraviado se trasladó hasta las instalaciones de la Fiscalía Regional de Justicia del 15 Distrito con sede en Orizaba, en dónde de igual forma presentó una denuncia por robo en contra de quién o quienes resulten responsables.
Con 2 mil 249 homicidios dolosos reportados por las autoridades estatales y federales, abril concluyó como el mes con más violencia letal en lo que va del presente año, un promedio de 78.3 casos diarios, de acuerdo con las cifras compiladas por el Secretariado Ejecutivo del Sistema Nacional de Seguridad Pública (SESNSP).
A partir de los datos del informe Víctimas reportadas por el delito de homicidio (Fiscalías Estatales y Dependencias Federales), en marzo se registraron 2 mil 192 asesinatos, un promedio diario de 70.7 casos.
En enero fueron 2 mil 127 homicidios dolosos, 68.6 casos por día; mientras que en febrero se reportaron 2 mil 022 asesinatos, un promedio de 72.2 casos diarios.
De esta forma, en el primer cuatrimestre de 2024 se han denunciado, de manera preliminar, un total de 8 mil 690 asesinatos, para un promedio de 72.4 casos por día.
A partir de las cifras preliminares del SESNSP, Guanajuato es la entidad con más asesinatos, en lo que va del presente año, con mil 012 casos, seguido del Estado de México con 843, Baja California con 763, Chihuahua con 611 y Jalisco con 587, en los primeros lugares.
El último día de abril, Día de la Niña y el Niño en México, se cometieron 76 homicidios dolosos, de los cuales 10 fueron en Michoacán; Morelos y Guanajuato reportaron 6 casos, por entidad.
En Chihuahua, la Ciudad de México y Sonora se reportaron 5 asesinatos, por estado; en el Estado de México, Jalisco y Tabasco fueron 4 homicidios dolosos, por entidad.

JC PONCE/EXCÉLSIOR CIUDAD DE MÉXICO
Un hombre fue detenido por la Policía de Monterrey, Nuevo León, acusado de golpear a su hermana.
La agresión ocurrió ayer martes 30 de mayo a las 21:35 horas, en las calles Oviedo y Barcelona, en la colonia Bosques de las Cumbres
Los elementos de la P olicía de Monterrey realizaban un recorrido de prevención y vigilancia cuando recibieron un reporte del C4I4.
Al llegar, la afectada de 23 años les dijo a los oficiales que su hermano Diego, de 28 años, la golpeó porque ella no le quiso dar las llaves de una camioneta.
Sin embargo, ella logró escapar y pedir ayuda vía telefónica.
Los uniformados municipales llegaron en pocos minutos, logrando la detención del presunto agresor. Las autoridades señalaron que investigan al hombre por otro tipo de presuntas agresiones que recibió la víctima.
Diego fue trasladado a las instalaciones de la Policía de Monterrey, donde quedó a disposición del Ministerio Público.
DETIENEN A HERMANOS POR GOLPEAR A SU PAPÁ EN MONTERREY
ÁNGELES VELASCO/EXCÉLSIOR
CIUDAD DE MÉXICO
Una mujer, identificada como Stephanie Guadalupe “N”, de 22 años, intentó huir hacia las instalaciones de la Vocacional 3 del IPN en la colonia Valle de Ecatepec, cuando se percató de la presencia policial ya que sabía que vendía mariguana disfrazada en golosinas y postres.
La vendedora fue interceptada por los oficiales, quienes procedieron a inspeccionar sus pertenencias.
Durante la revisión, se encontraron galletas, brownies, dulces, hamburguesas y tres bolsas de hierba, todos presuntamente impregnados de cannabis.
SE LA LLEVARON AL MINISTERIO PÚBLICO
Tras la detención, Stephanie fue trasladada a la agencia del Ministerio Público, donde se inició una carpeta de investigación por delitos contra la salud.
El Gobierno de Ecatepec aprovechó la ocasión para reiterar el llamado a los ciudadanos a proteger a los jóvenes del área y promover valores cívicos y deportivos como medidas preventivas contra el uso de drogas.
También se instó a la población a realizar denuncias anónimas contra cualquier actividad relacionada con la venta o producción de estupefacientes.

El pasado 26 de abril dos hermanos fueron detenidos por la Policía de Monterrey luego de que golpearan a su papá.
Los hechos se reportaron ayer jueves a las 20:25 horas en las calles Narciso Mendoza y Lázaro Cárdenas, en la colonia Niño Artillero.
Ambas personas fueron identificadas como Luis Raúl y Miguel Andrés, ambos de 25 años de edad.
De acuerdo a las autoridades, los uniformados realizaban un recorrido de prevención y vigilancia, cuando per-
sonal del C4I4 les reportó un caso de violencia familiar. Al llegar al domicilio, se entrevistaron con el afectado de 41 años quien mencionó se encontraba en su casa con su hijo de 12 años, cuando llegaron ambos jóvenes y lo comenzaron a insultar, gritándole el por qué estaba en la vivienda.
Luego lo abalanzaron para golpearlo a puñetazos y patadas, causándole diversos hematomas en varias partes del cuerpo, por lo que el menor pidió auxilio a las autoridades vía telefónica.
Disfrazaba postres y dulces con mariguana, los vendía frente a Voca



EL UNIVERSAL TUXTEPEC, OAX
El gobierno de Oaxaca, a través del secretario de Seguridad Pública y Protección Ciudadana de Oaxaca, Iván García Álvarez, confirmó la localización de cinco fosas clandestinas con los restos de ocho personas, cuatro hombres y cuatro mujeres, en predios a un costado de la carretera Loma Bonita- Playa Vicente, lo cual habían denunciado medios regionales, pero no había sido confirmado. Una de las fosas fue hallada al interior del rancho del productor piñero y activista político de Morena, Daniel Galán
Hernández, quien aspiró en 2021 a la alcaldía de Chacaltianguis, municipio de Veracruz a 30 kilómetros de la frontera con Oaxaca.
La dependencia informó que este rancho está ubicado en el tramo carretero de Loma Bonita, Oaxaca, y el municipio veracruzano de Sayula de Alemán, sobre la carretera federal 145, en este lugar se encontraron dos cuerpos.
En un segundo punto se encontraron cuatro fosas con otros seis cuerpos enterrados en el tramo de Loma Bonita- El Mixtán, en ranchos de David Lagunés Malpica y Guillermo Cotera Lagunés, productor piñero y empresario lomabo-
REDACCIÓN
VERACRUZ
Un juez de control de este distrito judicial, emitió vinculación a proceso en contra de Jesús Leonardo “N” como probable responsable del delito de feminicidio en agravio de su pareja.
Hechos ocurridos en la colonia Lomas de Rio Medio III, en esta ciudad, cuando probablemente participó en la muerte de su concubina.
El juez dictó como medida cautelar prisión preventiva justificada por un año y estableció seis meses para la investigación complementaria, dentro del proceso penal 246/2024.

nitense respectivamente, detalló el funcionario.
El jueves pasado en medios de comunicación regionales se documentó la llegada de fuerzas especiales que se acreditaron como una unidad de alto impacto, a realizar el cateo en los ranchos fronterizos en el ejido de Palmilla y el paraje de Los Mangos en los límites con Playa Vicente, Veracruz. En este operativo, según fuentes locales, también participó la Guardia Nacional y el Ejército, sostuvo el titular de seguridad.
De acuerdo con el dictamen de los peritos de la Fiscalía General del Estado de Oaxaca, los cuerpos encontrados tie-

por incumplimiento de la obligación de dar alimentos
REDACCIÓN CÓRDOBA
Un juez de control de este distrito judicial, emitió vinculación a proceso en contra de Jorge Lucio “N” como probable responsable del delito de incumplimiento de la obligación de dar alimentos en agravio de su hijo.
El juez dictó como medida cautelar presentación periódica por el tiempo que dure el proceso y estableció tres meses para la investigación complementaria, dentro del proceso penal 326/2023.
nen aproximadamente un año de estar en estado de descomposición. Playa y su influencia en Tuxtepec Playa Vicente es un municipio fronterizo entre Oaxaca y Veracruz, ubicado a 60 kilómetros y una hora de distancia en vehículo de la ciudad de Tuxtepec. Es una zona conocida por los pobladores por ser un bastión del crimen organizado a lo largo de los años, también es sabido cómo desde ese punto fronterizo con Veracruz la delincuencia ha ido controlando el norte de Oaxaca.
Tan sólo entre el 23 y el 27 de enero de 2020, desaparecieron 10 personas en el municipio de Playa Vicente.
REDACCIÓN LAS CHOAPAS
Un juez de control de este distrito judicial emitió vinculación a proceso en contra de Sandy “N” como probable responsable del delito de amenazas en agravio de la víctima identificada con las iniciales I.T.G.Z. Hechos ocurridos el 3 de mayo del 2021, cuando probablemente intentó atropellar a la víctima que viajaba en una motocicleta, pero al no lograrlo lo amenazó con privarlo de la vida.
El juez dictó como medida cautelar firma periódica de manera mensual y estableció dos meses para la investigación complementaria, dentro del proceso penal 406/2023.




